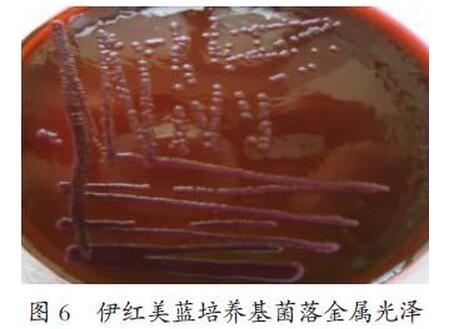
猪蓝耳病病毒、圆环病毒和大肠杆菌混合感染的诊断
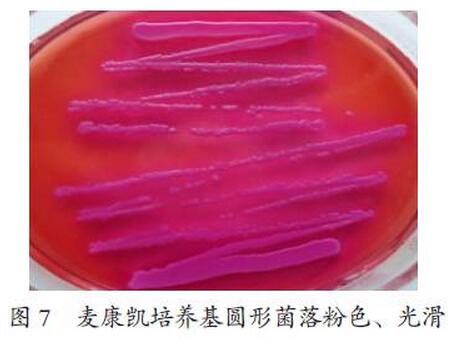
猪蓝耳病病毒、圆环病毒和大肠杆菌混合感染的诊断

猪繁殖与呼吸综合征(蓝耳病)病毒和圆环病毒是引起严重的种猪繁殖障碍的病原,而且经常以混合感染的形式出现,直接导致猪群的高发病率和高死亡率,控制难度增大,经济损失非常严重。本文通过对一例齐齐哈尔市某猪场病猪病例进行了临床症状分析和实验室诊断,确诊该病例为繁殖与呼吸障碍综合征、圆环病毒和大肠杆菌混合感染。
猪圆环病毒病(Porcinecircovirus disease)是由猪圆环病毒2型(Porcinecircovirus 2,PCV2)导致的患病猪全身性淋巴结肿大为特征的多系统器官功能衰竭的一类疾病的统称。临床上的主要表现为断奶仔猪多系统衰竭综合征(PMWS),猪呼吸疾病综合征(PRDC)、新生仔猪先天震颤(CT)。不同年龄的猪都可感染猪圆环病毒,病猪可通过鼻液、粪便等排泄物排出病毒,经口腔和呼吸道途径可传染给健康的猪。
猪蓝耳病(PRRS)称为“神秘猪病”、 “猪繁殖与呼吸综合征”等,我国将其列为二类传染病。本病是一种高度接触性传染病,呈地方性流行。PRRSV只感染猪,各种品种、不同年龄和用途的猪均可感染,但以妊娠母猪和1月龄以内的仔猪最易感。患病猪和带毒猪是本病的重要传染源。主要传播途径是接触感染、空气传播和精液传播,也可通过胎盘垂直传播。易感猪可经口、鼻腔、肌肉、腹腔、静脉及子宫内接种等多种途径而感染病毒,猪感染病毒后2~14周均可通过接触将病毒传播给其他易感猪。从病猪的鼻腔、粪便及尿中均可检测到病毒。易感猪与带毒猪直接接触或与污染有PRRSV的运输工具、器械接触均可受到感染。感染猪的流动也是本病的重要传播方式。
猪大肠杆菌病是由致病性大肠杆菌引起猪的一种急性肠道传染性疾病。临床上主要表现为肠炎、肠毒血症等多种症状。常见的有仔猪黄痢、仔猪白痢和仔猪水肿病3种。这3种疾病可造成仔猪大量死亡或生长发育不良,成为养猪业发展的严重障碍之一
但是近几年, 猪病以病原的多重感染或混合感染为主要的形式出现,猪群发病多是以两种以上的病原体相互协同造成的,如猪瘟,猪蓝耳病和大肠杆菌。这样常导致猪群的高发病率和高死亡率,控制难度增大,经济损失非常严重。本文通过对一例齐齐哈尔市某猪场病猪病例进行了临床症状分析及实验室诊断,确诊该病例为圆环病毒、繁殖与呼吸障碍综合征和大肠杆菌混合感染。
1 临床症状
仔猪临床症状主要表现为少数仔猪可见耳部、体表皮肤发紫;腹泻,体温升高至40 ℃以上,呼吸困难,有时呈腹式呼吸,食欲减退或废绝,腹泻,有的仔猪口鼻奇痒,常用鼻盘、口端摩擦圈舍的壁栏,鼻有分泌物;有的发病仔猪呈“八字形”呆立,后躯瘫痪,逐渐消瘦;被毛粗乱,肌肉震颤,共济失调。
2 病理学诊断
主要病理变化淋巴结肿大特别是腹股沟淋巴结,扁桃体出血,喉头黏膜出血,心外膜有针尖大出血点。肺有出血点或块状淤血,脾脏肿大有出血点, 周边有梗死灶。肾苍白或土黄色, 皮质有散在针尖大小出血点。肠道回盲口处有出血。膀胱黏膜出血。



3 病毒实验室诊断
以组织中提取的病毒DNA以及病毒RNA反转录的cDNA为模板,分别选用圆环病毒、猪蓝耳病毒和猪瘟病毒的特异性引物进行PCR鉴定。PCR结果经琼脂糖凝胶电泳分析如图4所示。

琼脂糖凝胶电泳发现,在加样孔 3的230 bp处看到清晰条带,与猪蓝耳病毒引物的目的片段大小相符;在加样孔5的493 bp处看到清晰条带,与圆环病毒引物的目的片段大小相符。
4 细菌学检测
将病料中所分离的细菌进行纯培养,进行革兰氏染色、涂片、镜检。可见到革兰氏染色阴性杆菌,中等大小,直杆菌(见图5)。由于大肠杆菌和沙门氏菌的形态及染色特征十分相似,所以为了区分这2种细菌,又分别接种于伊红美蓝和麦康凯培养基进行鉴别培养,结果为麦康凯培养基长出粉色,光滑,圆形菌落;在伊红美蓝培养基长出紫黑色,金属光泽菌落(见图6,图7)。

5 生化鉴定
结果见表1。

6 讨论
通过严格的实验室诊断和病理学诊断结合临床症状确定该病例为猪繁殖与呼吸障碍综合征和猪圆环病毒的混合感染。
通过对该猪场进行了全面的检查。发现该猪场这次暴发猪蓝耳病并发圆环病毒,引起大量仔猪发病并不是偶然的,而是与该养猪场的饲养管理和环境因素密切相关。经了解发现该场选购的猪苗、引进的种猪来自四面八方,而且只免疫了猪蓝耳病、猪丹毒、猪肺疫疫苗并没有免疫圆环病毒疫苗。同时猪场养殖密度过大、舍间距不科学、消毒不规范,遇到应激时易使潜在的疫病暴发。
同时我们利用自己平时所学知识和参考相关的书籍,最后在老师的帮助下也给他们提供了防治措施。
1)全面消毒:对猪舍进行一次全面的消毒,并坚持每周对猪舍消毒2次。
2)紧急接种:对无明显症状的猪,紧急免疫猪蓝耳病疫苗。
4)辅助治疗:本病使用抗生素治疗无效,只能用其控制或治疗并发感染,可配合使用猪白细胞干扰素、白细胞介导素、免疫球蛋白、高免血清等广谱抗病毒的生物制剂进行治疗,并使用黄芪多糖、甘草合剂等增强免疫力的药物进行辅助治疗。
5)加强猪场管理:平时要注意对猪场的管理,定期对畜舍,用具等设施灭菌消毒,禁止与猪场不相关的人、交通工具等随便出入,防止外来病毒传染,注意对病死猪的处理,要及时消毒火化或掩埋,发现疫情及时上报并隔离宰杀,不让疫情进一步扩散,对周边的猪场及时进行免疫接种,做好预防工作。
通过这次发病情况提醒广大养殖户朋友们,有条件的养殖户应实行自繁自养、全进全出;选购的猪苗应来自清洁无病的猪场,仔猪发生猪蓝耳病后,机体抵抗力降低,并可引起免疫抑制,易与其他病原混合感染。
7 结论
通过对该猪场的临床诊断、病理解剖以及实验室诊断发现该猪场的猪群感染了猪繁殖与呼吸障碍综合征、猪圆环病毒和大肠杆菌。
















